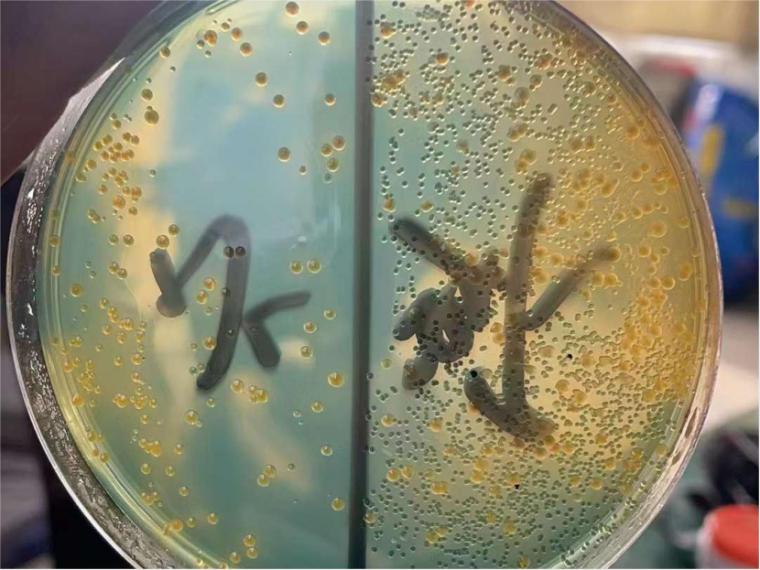

冬棚虾进入冲刺阶段,此时大家最忌惮的应该就是 弧菌了。弧菌的可怕之处就是能造成南美白 对虾肝胰腺的急性坏死,迅速造成对虾大量伤亡。大家习惯性地关注水底和水质当中的弧菌密度是正确的,但往往忽视对虾体内的弧菌。 在实际 养殖中,是有可能出现水质中的弧菌密度在安全范围,而对虾仍然出现弧菌突然爆发的情况,这时候再去关注对虾,往往已经回天乏术了。 
弧菌导致的肝胰腺坏死其实跟白便综合征一样,都是南美白对虾养殖中典型的细菌性疾病。跟它天生摄食选择性差有直接关系,摄食是它的主要感染途径,比如含有弧菌病原的死亡对虾、腐败生物絮团和有机颗粒物,甚至粪便等。
所以高品质投入品以及池塘颗粒物活性的保持是防控对虾弧菌爆发的主要措施,而且抑制肠道弧菌就是防御弧菌爆发的最后一道防线。 在冬棚虾冲刺季建议采取以下几点措施 1. 建立生物絮团生态系统,维持有活性的细菌和藻类,土池总菌量每毫升大于10的5次方个,工厂化等高集约化模式总菌量建议每毫升大于10的七次方个。每2-4天补充一次多矿以及碳源。 
2. 及时有效的底层排污和表层排污,必要时借助化学改底,来消除池塘中的腐败颗粒物。 3. 适量补充新鲜水。 4. 适时消毒,并及时补充有益菌,减少外源弧菌的输入。 5. 投喂高品质 饲料,并定期添加猎弧组合(乐畅+活力多),植物精油和酸制剂强强联合,压制弧菌等有害菌,保护肠道最后一道防线。 
冬棚虾效益喜人,千万别失误在养殖后半段。希望养虾人喜获丰收! (文章来源龙昌动保,由龙昌 水产焦点整理发布,更多养殖交流17615838221)
|